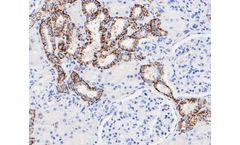
Huabio - Model CLDN7  -6-G3 M1412-2 - Mouse Monoclonal Antibody

- Home
- Equipment
Refine by
Huabio Environmental Equipment & Supplies
2 equipment items found
by:Huabio based inWoburn, MASSACHUSETTS (USA)
Western blot analysis on SW480 cell lysates using anti- CLDN7 mouse mAb. Immunohistochemical analysis of paraffin-embedded Human kidney using anti-CLDN7 antibody. The section was pre-treated using heat mediated antigen retrieval with Tris-EDTA buffer (pH 8.0-8.4) for 20 minutes.The tissues were blocked in 5% BSA for 30 minutes at room temperature, washed with ddH2O and PBS, and then probed with ...
by:Huabio based inWoburn, MASSACHUSETTS (USA)
Monoclonal antibodies (mAbs) are created by immunizing a mouse with a target antigen, thereby eliciting an immune response. The B lymphocytes, taken from the immunized mouse spleen, produce antibodies to the antigen. Each B lymphocyte is then fused with an immortal myeloma cell line, allowing the production of unlimited quantities of ...